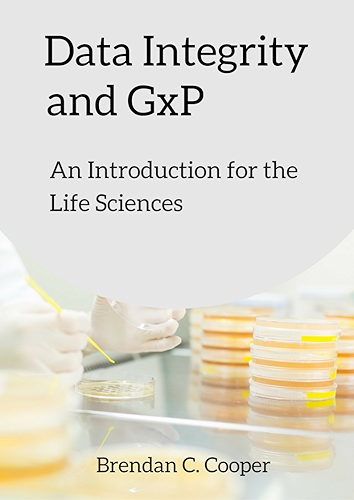
Download Data Integrity and GxP: An Introduction for the Life Sciences  (English Edition) PDF

[Télécharger] Data Integrity and GxP: An Introduction for the Life Sciences (English Edition) de Brendan Cooper Francais PDF
Télécharger Data Integrity and GxP: An Introduction for the Life Sciences (English Edition) de Brendan Cooper Pdf Epub
Télécharger "Data Integrity and GxP: An Introduction for the Life Sciences (English Edition)" de Brendan Cooper Livre PDF Gratuit
Auteur : Brendan Cooper
Catégorie : Boutique Kindle,Ebooks Kindle,Ebooks en langues étrangères
Broché : * pages
Éditeur : *
Langue : Français, Anglais
This concise pocket book the perfect introduction to Data Integrity in a GxP environment. It summarises key definitions and concepts from FDA and Eudralex regulatory requirements. Data Integriy and Data Reliability are increasingly seen as a critical aspect in ensuring patient health and safety. This book clearly outlines the fundamentals of Data Integrity, required to be Accurate, Attributable, legible, contemporaneously recorded and original (ALCOA). In addition, the requirements of Computerised systems are summarised through a lifecycle approach. All-in-all a concise guide for any Engineering or Science professional. (Size 5" x 8" Paperback)
Télécharger Data Integrity and GxP: An Introduction for the Life Sciences (English Edition) de Brendan Cooper Livres En Ligne
Google Livres ~ Livres. Effectuez des recherches dans l'index de livres complets le plus fourni au monde. Ma bibliothèque. Éditeurs À propos Confidentialit é Conditions d'utilisation Aide .
Pharmaceutical Facility Publications and Guidance ~ GAMP Guide: Records & Data Integrity GAMP Good Practice Guides GAMP 5: A Risk-Based Approach to Compliant GxP Computerized Systems provides pragmatic and practical industry guidance that aims to achieve compliant computerized systems that are fit for intended use in an efficient and effective manner, while also enabling innovation and technological advances.
Livres sur Google Play ~ Profitez de millions d'applications Android récentes, de jeux, de titres musicaux, de films, de séries, de livres, de magazines, et plus encore. À tout moment, où que vous soyez, sur tous vos appareils.
Free Ebooke Library- ebook library free download, Download ~ Download free pdf or zip ebooks, or read online ebooks. Library of free ebooks available under free ebooks licenses such as GFDL, Creative Commons license, Project Gutenberg-tm License, other freedom to use and distribution licenses. So get free ebook and download pdf
Publications ~ Draft PIC/S Good Practices for Data Management and Integrity in Regulated GMP/GDP Environments : PI 041-1 (Draft 3) Documents for Inspectors: Guidance documents: Press Release October 2018 : PR October 2018: Documents for the public: Press releases: PIC/S GMP Guide (Introduction) PE 009-14 (Intro) Documents for Industry: PIC/S GMP Guide: PIC/S GMP Guide (Part I: Basic Requirements for .
Google ~ Search the world's information, including webpages, images, videos and more. Google has many special features to help you find exactly what you're looking for.
Chromeleon™ Chromatography Data System (CDS) Software ~ Streamline your laboratory workflows using Thermo Scientific Chromeleon Chromatography Data System (CDS) software. Built with both the lab and IT in mind, this software delivers superior compliance tools, networking capabilities, instrument control, automation, data processing, and much more. It's a
Lifesize: Video Conferencing System & Meeting Room Solutions ~ Lifesize is a purpose-built video conferencing solution for the modern business. Try our industry-leading app for free! See why Lifesize is used by organizations around the world to connect anyone, anywhere, on any device or in any meeting room.
Google Traduction ~ Ce service gratuit de Google traduit instantanément des mots, des expressions et des pages Web du français vers plus de 100 autres langues.
Google 翻译 ~ Google 的免费翻译服务可提供简体中文和另外 100 多种语言之间的互译功能,可让您即时翻译字词、短语和网页内容。
Furet du Nord : Livres, Ebooks et Produits Culturels ~ Librairie en ligne Furet du Nord : tous les livres en version papier ou numérique. Livraison à domicile, en point relais ou en magasin. Livres, ebooks, produits culturels.
Anaconda / Individual Edition ~ Anaconda Individual Edition is the world’s most popular Python distribution platform with over 20 million users worldwide. You can trust in our long-term commitment to supporting the Anaconda open-source ecosystem, the platform of choice for Python data science.
Cultura - Articles Culturels et Loisirs Créatifs ~ Cultura vous propose de nombreux produits culturels et loisirs créatifs. Achetez en ligne vos livres, DVD, jeux vidéos, instruments de musique et billets de spectacles. Nourrissez votre matière grise à moindre prix sur Cultura. Livraison offerte le lendemain en magasin.
Nouvelles polices / dafont ~ Polices à télécharger. Voir les variantes. Taille
Livres PDF - Home / Facebook ~ Livres PDF. 3.8K likes. Livres PDF telecharger gratuit. Télécharger Le Temps des Tempêtes PDF. Télécharger Le Temps des Tempêtes EPUB, PDF Gratuitement, Télécharger Le Temps des Tempêtes PDF vos Ebook Gratuit français Gratuitement en format Epub, PDF, Kindle et utiliser votre lisseuse préférée pour les lire.
MCreator - The Best Minecraft Mod Maker Ever ~ MCreator is open source software used to make Minecraft Java Edition mods, Bedrock Edition Add-Ons, and data packs using an intuitive easy-to-learn interface or with an integrated code editor. It is used worldwide by Minecraft players, mod developers, for education and by STEM workshops.
Accueil - Archive ouverte HAL ~ Archive ouverte HAL. L'archive ouverte pluridisciplinaire HAL, est destinée au dépôt et à la diffusion d'articles scientifiques de niveau recherche, publiés ou non, et de thèses, émanant des établissements d'enseignement et de recherche français ou étrangers, des laboratoires publics ou privés.. À l'attention du déposant. Le dépôt du texte intégral est effectué en accord avec .
Google Scholar ~ Google Scholar provides a simple way to broadly search for scholarly literature. Search across a wide variety of disciplines and sources: articles, theses, books, abstracts and court opinions.
Scoop - Content Curation Tool / Scoop ~ Scoop enables professionals and businesses to research and publish content through its content curation tool.
Box - Gestion de contenu, processus de travail et ~ Grâce à Box, vous pouvez gérer, sécuriser, partager et réguler tout votre contenu à partir d'un seul espace, pour vos collaborations ou opérations internes comme externes.
Les Sims™ 4 - Site officiel - Official EA Site ~ Tu crées. Tu choisis. Tu maîtrises dans Les Sims 4. Crée de nouveaux Sims avec de fortes personnalités et des apparences distinctes. Contrôle l'esprit, le corps et le cœur de tes Sims et joue avec la vie dans Les Sims 4.
Télécharger - Logiciel Internet gratuit - Comment Ça Marche ~ Google Chrome. La version actuelle de Google Chrome est la 87.0.4280.66 publiée. Licence : Gratuit OS : Windows 7 Windows 8 Windows 10
Google Play ~ NASB, Charles F. Stanley Life Principles Bible, 2nd Edition, Ebook: Holy Bible, New American Standard Bible, Edition 2 Thomas Nelson The Charles F. Stanley Life Principles Bible, with over a million sold to date, is designed to lead believers into a life-changing relationship with Jesus Christ, and to help them experience the Good News about God’s mighty kindness and love.
Rethinking the relationship between plagiarism an… – Revue ~ Rethinking the relationship between plagiarism and academic integrity. Un article de la revue Revue internationale des technologies en pédagogie universitaire / International Journal of Technologies in Higher Education (Du plagiat à l’intégrité académique : quelles compétences, quelles stratégies?) diffusée par la plateforme Érudit.
Notice et manuel d'utilisation, modes d'emploi, notices ~ Bienvenue sur le site gratuit manuel-notice, le spécialiste du téléchargement de manuels. L'idée initiale du site repose sur un constat simple : comment regrouper et centraliser au mieux les modes d'emploi, que nous avons tous un jour ou l'autre égarés ou que nous n'avions tout simplement jamais eu, et les proposer en téléchargement gratuit aux internautes.
Post a Comment for "[Télécharger] Data Integrity and GxP: An Introduction for the Life Sciences (English Edition) de Brendan Cooper Francais PDF"